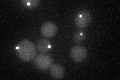
YDR130C
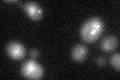
YDR130C

View description
Spindle pole body-related intermediate filament protein, forms cell cycle-specific filaments between spindle pole bodies in mother and daughter cells, able to self-assemble, expression induced during S/G2, localization cell-cycle dependent
Localization:
Intensity:
Fold change:
Significance:
-
C’ GFP library in SD
punctate20.31 -
N' NOP1pr-GFP in SD

punctate,nucleus31.6245 -
N' TEF2pr-mCherry in SD

cell periphery,vacuole0 -
N' NATIVEpr-GFP in SD

punctate,nucleus22.124 -
N' TEF2pr-VC and Cyto-VN in SD

#N/A0 -
C’ GFP library in SD+DTT
punctate20.130.99No -
C’ GFP library in SD+H2O2

punctate17.840.87No -
C’ GFP library in Starvation Media

cytosol14.420.71No -
C’ GFP library on the background of Pup2-DaMP

punctate -
C’ GFP library on the background of CCT mutant

punctate19.71980.970491No
